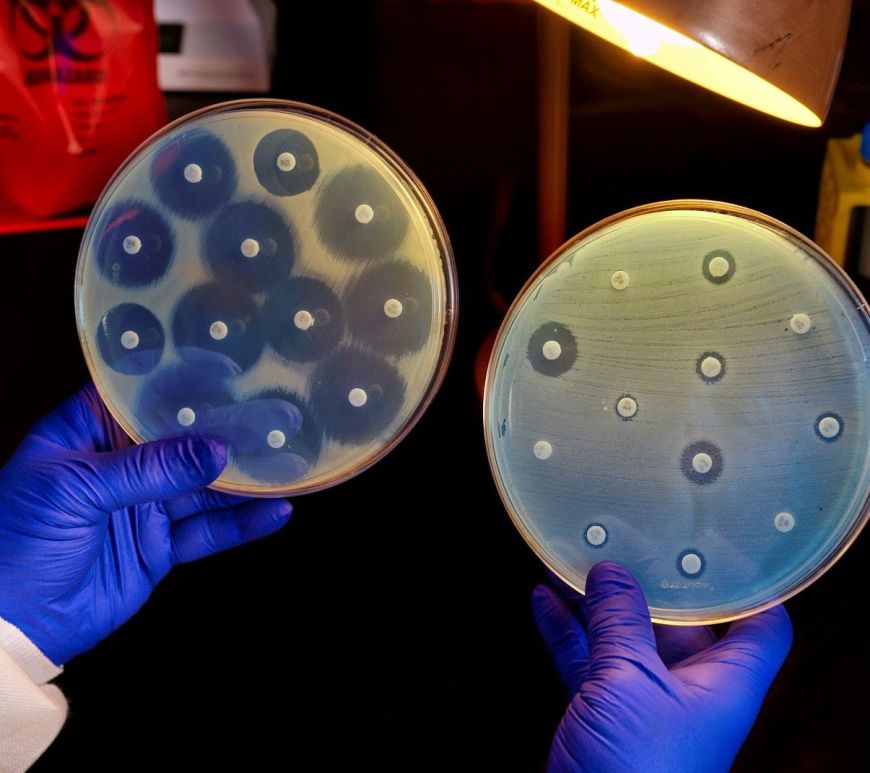

¿Qué son las Ciencias Naturales?
Descubre qué son las Ciencias Naturales, cuáles son sus ramas, por qué son importantes y su papel en la educación y la ciencia. Continúa leyendo ¿Qué son las Ciencias Naturales?

Descubre qué son las Ciencias Naturales, cuáles son sus ramas, por qué son importantes y su papel en la educación y la ciencia. Continúa leyendo ¿Qué son las Ciencias Naturales?

¿Alguna vez te has preguntado qué pasaría si el agua tuviera altas concentraciones de sustancias anticonceptivas, antibióticos, agentes quimioterapéuticos y otros medicamentos?
Descubre cómo la contaminación del agua por fármacos es una realidad que podría tener efectos catastróficos si no se controla a tiempo. Continúa leyendo La contaminación del agua por fármacos

Los efectos de las bombas atómicas no se limitaron a los observados al momento de su caída y aún en nuestros días, siguen permeando en la cultura mundial. En este articulo revisamos los efectos que las bombas tuvieron a largo plazo sobre sus sobrevivientes y como fue la vida para ellos tras la guerra. Continúa leyendo Lo que la bomba atómica se llevó: La historia de los hibakusha (Parte II)

La Segunda Guerra Mundial representa uno de los momentos más turbulentos de la humanidad. Dentro de este episodio, la bomba atómica fue uno de sus eventos cúlmines. En este articulo revisamos los efectos de las bombas atómicas sobre el suelo japonés y los preparativos que llevaron a ello. Continúa leyendo Lo que la bomba atómica se llevó: La historia de los hibakusha (Parte I)

Los resurreccionistas: Cómo la medicina del siglo XIX permitió la exhumación y venta de cuerpos para desenterrar el conocimiento de la anatomía humana. Continúa leyendo El oficio de la muerte: Los resurreccionistas

😯 Toca hablar de un tema controversial, ¿puede llegar a matarte el uso de marihuana? 🔎 Continúa leyendo Marihuana ¿Puede matarme? – Síndrome de hiperémesis por cannabinoides
Las bacterias pueden mutar por el uso de antibióticos generando resistencia al no responder ante el uso de estos, por lo que siguen multiplicándose, amenazando gravemente a la salud mundial. ¿Quieres saber más? ¡Sigue leyendo aquí! Continúa leyendo Resistencia a antibióticos: amenaza para la salud mundial

La leche es uno de los alimentos más comunes en la mesa. Desde licuados, cremas, productos helados y más, este líquido nutritivo lo hallas en cualquier hogar del mundo, independientemente de si eres o no intolerante a la lactosa. También, de ella (entre otras sabrosas viandas), puedes encontrar la vitamina D. Y me pregunto si su descubridor, Edward Mellanby, la hubiera recomendado a los demás. Continúa leyendo ¿Habría sugerido Edward Mellanby leche en la dieta?